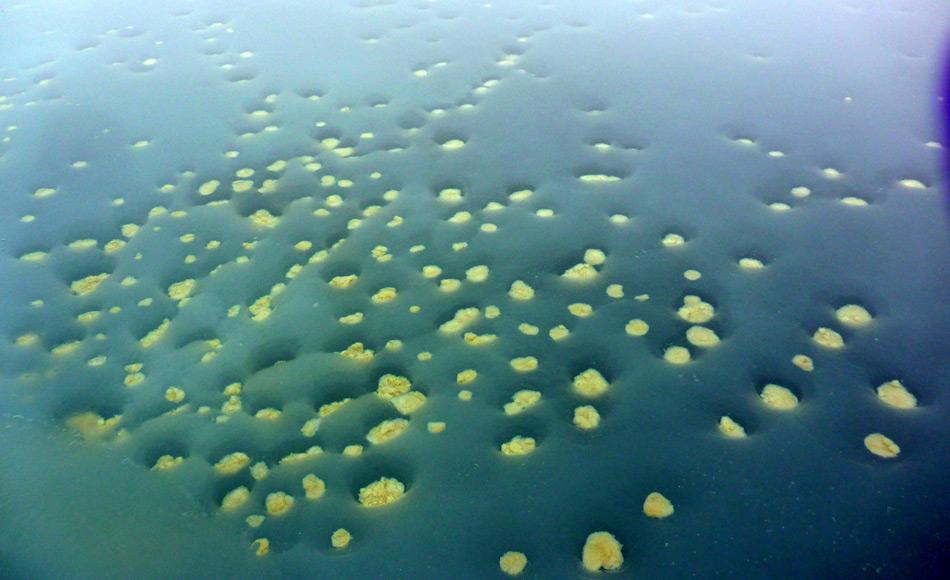
Die Meereisalge Melosira ist eine der wichtigsten Algenvertreter in der Arktis. Sie widersteht den eisigen Bedingungen und braucht sogar die Eisbildung in ihrer Entwicklung. Dieses Bild zeigt die Überreste abgestorbener Eisalgen, die sich am Grund eines Schmelztümpels abgelagert haben. (Foto: Mar Fernández-Méndez)

Ohne Eis kein Futter für Polardorsche
Im arktischen Nahrungsnetz nimmt der Polardorsch eine Schlüsselrolle ein: Von ihm ernähren sich Wale, Robben und Seevögel gleichermaßen. Doch dem Polardorsch selbst könnte die Nahrungsgrundlage bald fehlen. Unter dem zentralarktischen Meereis sind die Jungfische nämlich indirekt, aber in hohem Maße von Eisalgen abhängig. Somit könnte der Rückgang des Meereises weitreichende Folgen für das Nahrungsnetz haben. Diesen Zusammenhang haben Forscher seit längerem vermutet. Jetzt ist einem internationalen Forscherteam unter der Federführung des Alfred-Wegener-Instituts, Helmholtz-Zentrum für Polar- und Meeresforschung (AWI) der Nachweis gelungen.

Das arktische Meereis ist die Kinderstube der Polardorsche: Die Jungfische im Alter von ein bis zwei Jahren leben in den Hohlräumen unter und zwischen den Schollen und treiben mit der Eisdecke mit. So gelangen sie vermutlich aus den Laichgebieten des Polardorsches in den Gewässern nördlich Sibiriens in die zentrale Arktis. Während dieser Reise fressen die jungen Polardorsche Kleintiere wie Floh- und Ruderfußkrebse, die sich wiederum von Eisalgen ernähren. Dadurch besteht ein unmittelbarer Zusammenhang zwischen den Polardorschen und den Eisalgen, der langfristig das Überleben der jungen Polardorsche gefährden kann. Zu diesem Ergebnis kommt eine Studie, die jetzt im Fachmagazin „Progress in Oceanography“ erscheint und an der neben dem AWI unter anderem das Forschungsinstitut Wageningen Marine Research in den Niederlanden beteiligt war. „Insgesamt zeigen unsere Ergebnisse eine starke Abhängigkeit der Polardorsche von Eisalgen“, sagt Erstautorin und AWI-Biologin Doreen Kohlbach. „Das bedeutet, dass der rasante Rückgang des arktischen Meereises junge Polardorsche besonders gefährdet. Wenn das Meereis zurückgeht, fehlt den Polardorschen die Nahrungsgrundlage. Aufgrund der Schlüsselrolle, die sie im Nahrungsnetz einnehmen, können sich diese Veränderungen auf das gesamte Nahrungsnetz auswirken.“
Für ihre Studie haben Doreen Kohlbach und ihre KollegInnen den Mageninhalt der Fische analysiert. Diese hatten sie im Spätsommer 2012 während einer mehrwöchigen Expedition mit dem Forschungsschiff Polarstern im Arktischen Ozean direkt unterhalb des Meereises gefischt. Zwischen Grönland, Spitzbergen und Russland zogen die Wissenschaftler ein speziell entwickeltes Unter-Eis-Netz kilometerweit neben dem Schiff her. Der Mageninhalt zeigte den Forschern, was die Fische vor Kurzem gefressen hatten. Das Ergebnis: Ganz oben auf dem Speiseplan der jungen Polardorsche steht der Flohkrebs Apherusa glacialis. Er machte den größten Anteil des Mageninhaltes aus. Der Flohkrebs selbst wiederum ernährt sich zu einem Großteil von Kieselalgen, welche direkt im oder unter dem Meereis wachsen. In einem zweiten Schritt wiesen die Forscher Kohlenstoff aus eben diesen Eisalgen in den Fischen nach. Dafür analysierten sie Fettsäuremuster und die Zusammensetzung stabiler Isotope im Muskelfleisch und Gewebe der Polardorsche. Bestimmte Fettsäuren werden in der Nahrungskette von den Algen zu den Konsumenten unverändert weitergegeben. „Wenn wir im Fleisch oder Gewebe eines Fisches die Fettsäuren der Eisalgen finden, bedeutet das, dass der Fisch selbst oder seine Beutetiere sich von den Algen ernährt haben“, sagt Doreen Kohlbach. Die Isotopen-Analyse ermöglicht dann die Bestimmung des genauen Anteils an Eisalgenkohlenstoff an der Nahrung der Fische.

„Die Auswertung zeigt, dass Kieselalgen die wichtigste Kohlenstoff-Quelle für Polardorsche sind“, so Doreen Kohlbach. Demnach stammten zwischen 50 und bis zu über 90 Prozent des Kohlenstoffbedarfs der jungen Polardorsche aus Eisalgen. „Auch wenn wir am Anfang unserer Studie einen Zusammenhang zwischen Eisalgen und Polardorschen angenommen hatten, so haben uns diese hohen Werte doch sehr überrascht.“ Bereits im vergangenen Jahr konnten die Wissenschaftler nachweisen, wie sehr Eisalgen auch Tierarten als Nahrung dienen, die vorwiegend in größeren Wassertiefen vorkommen. Mit der jetzigen Studie liefern sie den Nachweis, dass sich diese Abhängigkeit im nächsten Schritt der Nahrungskette fortsetzt. Beide Studien liefern wichtige Zahlen, die in Ökosystem-Modelle einfließen. Diese sind für Vorhersagen wichtig, wie sich der Rückgang des Meereises auf das arktische Ökosystem auswirkt.
Quelle: Alfred-Wegener-Institut, Bremerhaven